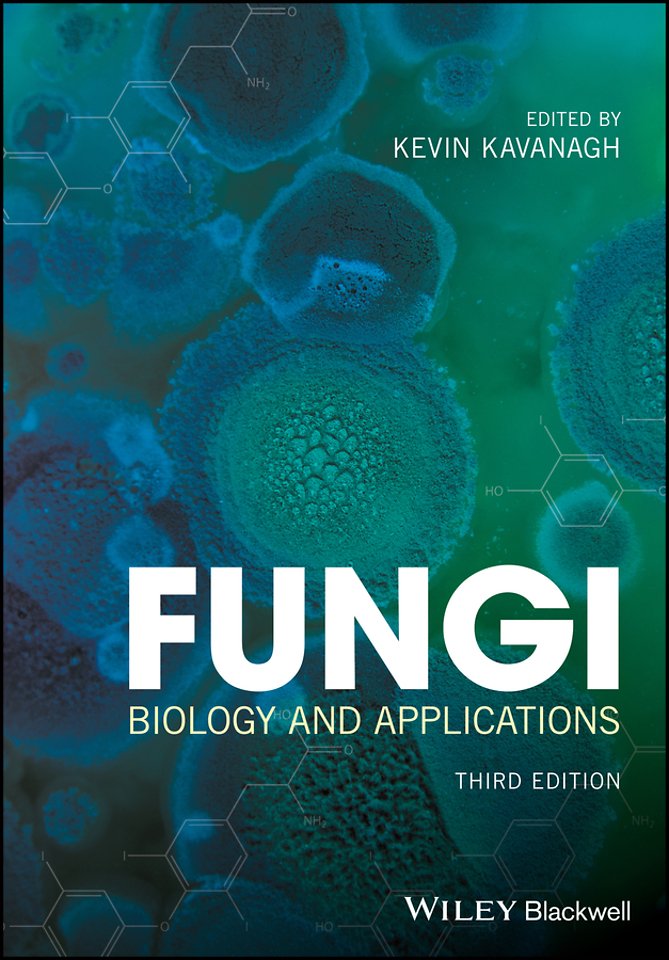
Fungi

Fungi
Biology and Applications
Specificaties
Paperback, 416 blz.
|
EN
John Wiley and Sons Ltd |
e druk, 2017
ISBN13: 9781119374329
Rubricering
Levertijd ongeveer 15 werkdagen